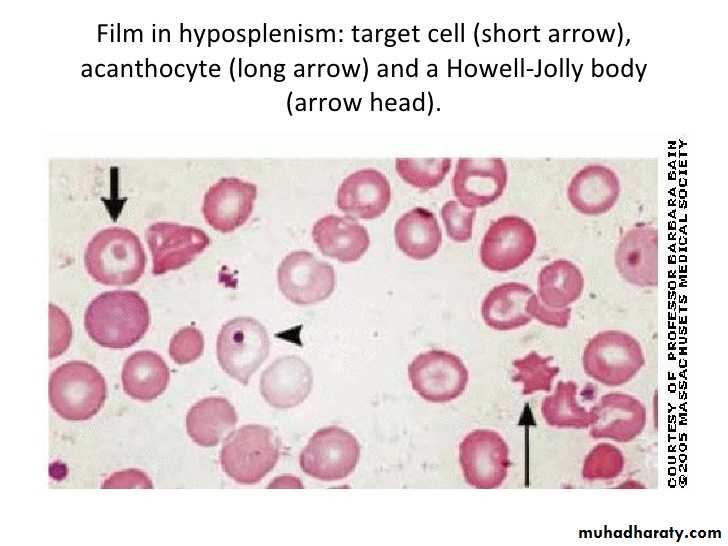

4th stage
Medicine(Small intestine)Lec-1
Dr.Al-Youzbaki
4/20/2016
DISEASES OF THE SMALL INTESTINEDisorders causing malabsorption: Coeliac disease
-Coeliac disease is an inflammatory disorder of the small bowel occurring in genetically susceptible individuals, which results from intolerance to wheat gluten and similar proteins found in rye, barley and, to a lesser extent, oats.-The condition occurs worldwide but is more common in northern Europe.
-The prevalence is approximately 1%,
-50% of these people are asymptomatic.
-‘silent’ coeliac disease ‘latent’ coeliac disease – genetically susceptible people who may later develop clinical coeliac disease.
Pathophysiology
presentation
-Celiac disease can present at any age.-In infancy:
it occurs after weaning on to cereals
typically presents with diarrhea, malabsorption and failure to thrive.
-older children:
non-specific features such as delayed growth.Features of malnutrition are found on examination and mild abdominal distension.
pubertal delay, leading to short stature in adulthood.
-In adults:
usually during the third or fourth decade
females > males.
The presentation is highly variable: florid malabsorption, while others develop non-specific symptoms, such as tiredness, weight loss, folate deficiency or iron deficiency anaemia. oral ulceration, dyspepsia and bloating. mild under-nutrition and osteoporosis.
Investigations
Duodenal biopsy: Endoscopic small bowel biopsy is the gold standard. The histological features are usually characteristic but other causes of villous atrophy should be considered.
Antibodies:
Anti tissue transglutamase antibodies and Anti-endomysial antibodies of the IgA :They are sensitive (85–95%) and specific (approximately 99%) for the diagnosis, except in very young infants.IgG antibodies, however, must be analysed in patients with coexisting IgA deficiency.
they usually become negative with successful treatment.
Haematology and biochemistry:
A full blood count may show microcytic or macrocytic anaemia from iron or folate deficiency and features of hyposplenism (target cells, spherocytes and Howell– Jolly bodies).
Biochemical tests may reveal reduced concentrations of calcium, magnesium, total protein, albumin or vitamin D.
Management
-Exclusion of wheat, rye, barley and initially oats, although oats may be re-introduced safely in most patients after 6–12 months.
-Frequent dietary counselling.
-Mineral and vitamin supplements.
-Measurement of tTG or anti-endomysial antibodies.
Complications
Risk of malignancy, particularly of enteropathy-associated T-cell lymphoma, small bowel carcinoma and squamous carcinoma of the esophagus.
Ulcerative jejuno-ileitis.
Osteoporosis and osteomalacia.
still diarrhea in spite of gluten free diet??
Non Compliance , Non Compliance ,…..Non compliance.
Associations : pancreatic insufficiency , microscopic colitis, inflammatory bowel disease.
Complications: ulcerative jejunitis , enteropathy associated T-cell lymphoma, small bowel carcinoma and refractory coeliac disease.
Dermatitis herpetiformis
-intensely itchy blisters over the elbows, knees, back and buttocks.-Immunofluorescence shows granular or linear IgA deposition at the dermoepidermal junction.
-Almost all patients have partial villous atrophy on duodenal biopsy, identical to that seen in coeliac disease, even though they usually have no gastrointestinal symptoms.
-The rash usually responds to a gluten free diet but some patients require additional treatment with dapsone.
Small bowel bacterial overgrowth(‘blind loop syndrome’)
-The normal duodenum and jejunum contain fewer than 10⁴/mL organisms, which are usually derived from saliva.
-The count of coliform organisms never exceeds 10⁴/mL.
-In bacterial overgrowth, there may be 108–1010/mL organisms, most of which are normally found only in the colon.
Clinical features
The patient presents with watery diarrhoea and/or steatorrhoea, with anaemia due to B12 deficiency. These arise because of deconjugation of bile acids, which impairs micelle formation, and because of bacterial utilisation of vitamin B12.Investigations
Barium follow-through .
Jejunal contents for bacteriological examination can also be aspirated at endoscopy (Gold standard) .
non-invasively using hydrogen breath tests.
Low serum levels of vitamin B12, with normal or elevated folate levels because the bacteria produce folic acid.
Management
Treatment of the underlying cause of small bowel bacterial overgrowthTetracycline (250 mg 4 times daily for 7 days) is then the treatment of choice, Metronidazole (400 mg 3 times daily) or ciprofloxacin (250 mg twice daily) is an alternative.
Some patients require up to 4 weeks of treatment and, in a few, continuous rotating courses of antibiotics are necessary.
Intramuscular vitamin B12 supplementation.
Whipple’s disease
-This rare condition is characterised by infiltration of small intestinal mucosa by ‘foamy’ macrophages, which stain positive with periodic acid–Schiff (PAS) reagent.
-Caused by infection with the Gram positive bacillus Tropheryma whipplei.
-The disease is a multisystem
Diagnosis:
characteristic features on small bowel biopsy, with characterisation of the bacillus by polymerase chain reaction (PCR).Management:
-often fatal if untreated .
-Responds well, at least initially, to intravenous ceftriaxone (2 g daily for 2 weeks), followed by oral co-trimoxazole for at least 1 year.
هاي الصورة موجودي بالـ بوربوينت مالي علاقة :))
Ileal resection-The most common scenario is in patients with Crohn’s disease.
-Diarrhea usually responds well to colestyramine, a resin which binds bile salts in the intestinal lumen. Aluminium hydroxide can be used as an alternative.
Short bowel syndrome
-Digestion and absorption are normally completed within the first 100 cm of jejunum, and enteral feeding is usually still possible if this amount of small intestine remains.
-The presence of some or all of the colon can markedly improve these losses by increased water reabsorption.
-The presence of an intact ileocaecal valve ameliorates the clinical picture by slowing small intestinal transit and reducing bacterialovergrowth.
Clinical features
Diarrhoea and steatorrhoea.
Dehydration and signs of hypovolaemia are common,
weight loss, loss of muscle bulk and malnutrition.
Management
-In the immediate post-operative period: total parenteral nutrition (TPN) should be started and PPI therapy given to reduce gastric secretions.-Enteral feeding should be cautiously introduced after 1–2 weeks under careful supervision and slowly increased as tolerated.
-If less than 75 cm of small bowel remains, TPN is also needed.
-Detailed nutritional assessments at regular intervals
-Monitoring of fluid and electrolyte balance.
-Adequate calorie and protein intake, Fats are a good energy source and should be taken as tolerated. Medium-chain triglyceride are given because they are more easily absorbed.
-Replacement of vitamin B12, calcium, vitamin D, magnesium, zinc and folic acid.
-Loperamide (2–4 mg 4 times daily) or codeine phosphate (30 mg 4–6 times daily) for diarrhoea.
-Octreotide (50–200 μg 2–3 times daily by subcutaneous injection) reduces gastrointestinal secretions.
-some require long-term home TPN for survival .
-Small bowel transplantation.
Radiation enteritis and proctocolitis
-The risk varies with total dose, dosing schedule and the use of concomitant chemotherapy.
-Acute injury: nausea, vomiting , abdominal pain and diarrhea . When the rectum and colon are involved, rectal mucus, bleeding and tenesmus occur. rectal changes at sigmoidoscopy resemble ulcerative proctitis or ulcerative colitis. Barium follow-through showing small bowel strictures, ulcers and fistulae
-Chronic Phase :Proctocolitis , Bleeding from telangiectasia, Small bowel strictures, Fistulae: rectovaginal , colovesical , enterocolic ; Adhesions, Malabsorption: bacterial overgrowth, bile salt malabsorption(ileal damage).
Management
-Diarrhoea : codeine phosphate, diphenoxylate or loperamide.-Local corticosteroid enemas can help proctitis.
-Antibiotics may be required for bacterial overgrowth.
-Nutritional supplements.
-Colestyramine (4 g as a single sachet) is useful for bile salt malabsorption.
-Endoscopic argon plasma coagulation therapy may reduce bleeding from proctitis.
-Surgery should be avoided, if possible, because the injured intestine is difficult to resect and anastomose, but may be necessary for obstruction, perforation or fistula.
ISCHAEMIC GUT INJURY
-Ischaemic gut injury is usually the result of arterial occlusion.
- Severe hypotension and venous insufficiency are less frequent causes.
-The presentation is variable, depending on the different vessels involved and the acuteness of the event.
- Diagnosis is often difficult.
Acute small bowel ischaemia
-An embolus from the heart or aorta to the superior mesenteric artery is responsible for 40–50% of cases, thrombosis of underlying atheromatous disease for approximately 25%, and non-occlusive ischaemia due to hypotension complicating myocardial infarction, heart failure, arrhythmias or sudden blood loss for approximately 25%. Vasculitis and venous occlusion are rare causes.
-The clinical spectrum ranges from transient alteration of bowel function to transmural haemorrhagic necrosis and gangrene. Almost all develop abdominal pain that is more impressive than the physical findings.
- In the early stages, the only physical signs may be a silent, distended abdomen or diminished bowel sounds, peritonitis only developing later.
-Leucocytosis, metabolic acidosis, hyperphosphataemia and hyperamylasaemia are typical.
-Plain abdominal X-rays show ‘thumb-printing’ due to mucosal oedema.
-Mesenteric or CT angiography reveals an occluded or narrowed major artery with spasm of arterial arcades, although most patients undergo laparotomy on the basis of a clinical diagnosis without angiography.
-Resuscitation, management of cardiac disease and intravenous antibiotic therapy, followed by laparotomy, are key steps.
- If treatment is instituted early, embolectomy and vascular reconstruction may salvage some small bowel.
-In these rare cases, a ‘second look’ laparotomy should be undertaken 24 hours later and further necrotic bowel resected.
-In patients at high surgical risk, thrombolysis may sometimes be effective.
Chronic mesenteric ischaemia
-This results from atherosclerotic stenosis of the coeliac axis, superior mesenteric artery and inferior mesenteric artery. At least two of the three vessels must be affected for symptoms to develop.
-The typical presentation is with dull but severe mid- or upper abdominal pain developing about 30 minutes after eating. Weight loss is common because the patient is reluctant to eat, and some experience diarrhoea.
-Physical examination shows evidence of generalised arterial disease.
-An abdominal bruit is sometimes audible but is non-specific.
-The diagnosis is made by mesenteric angiography.
-Treatment is by vascular reconstruction or percutaneous angioplasty, if the patient’s clinical condition permits.
-The condition is frequently complicated by intestinal infarction, if left untreated.